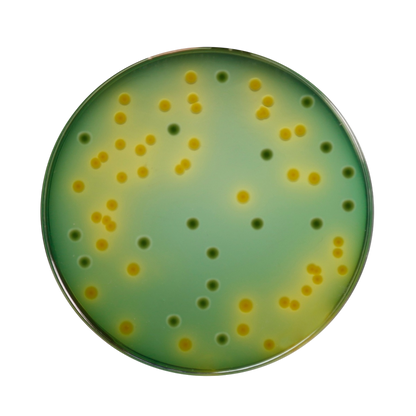
Himedia - TCBS Agar (M189-500G).
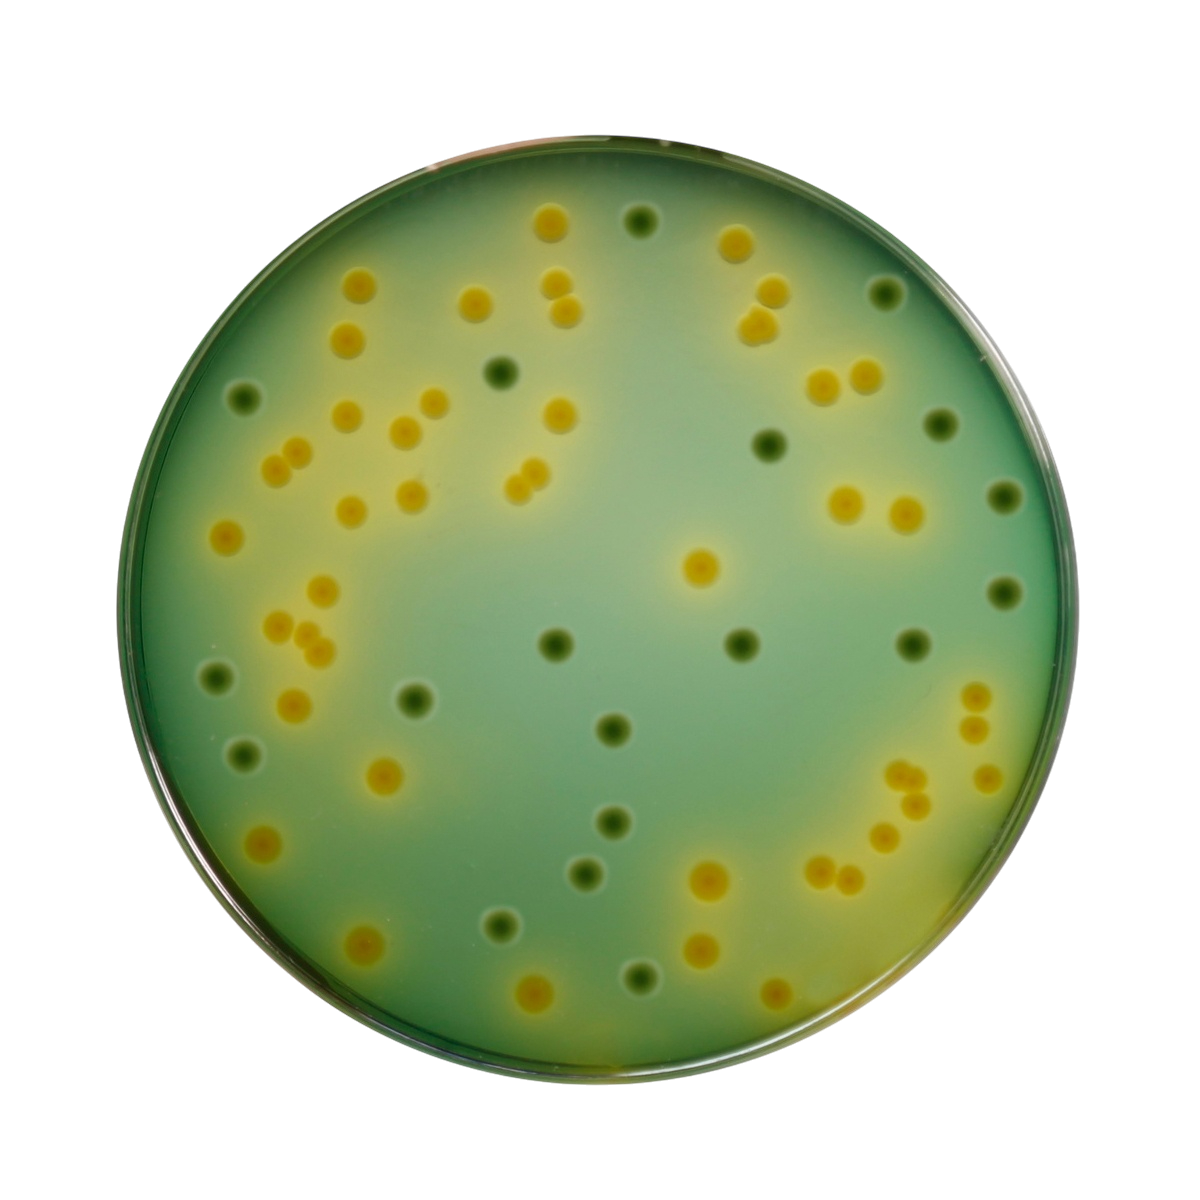
Himedia - TCBS Agar (M189-500G).

1
/
of
2
Himedia - TCBS Agar (M189-500G).
Himedia - TCBS Agar (M189-500G).
Regular price
Rs. 6,649.00
Regular price
Sale price
Rs. 6,649.00
Shipping calculated at checkout.
1 review
Couldn't load pickup availability
Quantity
- For the selective isolation and cultivation of Vibrio cholerae and other enteropathogenic Vibrios causing food poisoning from clinical and food specimens.
- APHA highly recommends this medium for the selective isolation of V. cholerae and V. parahaemolyticus. Enrichment in Alkaline Peptone Water (M618), followed by isolation on TCBS Agar, is routinely used for the isolation of V. cholerae.
Share
Collections
-
Laboratory Chemicals
“Discover high-purity laboratory chemicals for research, testing, and industrial applications — trusted...
-
Industrial and Hand tools
“Explore our range of durable hand tools and reliable hardware designed for...
S
Syed Ziahul Haq Mohamed Yousoff Very good.